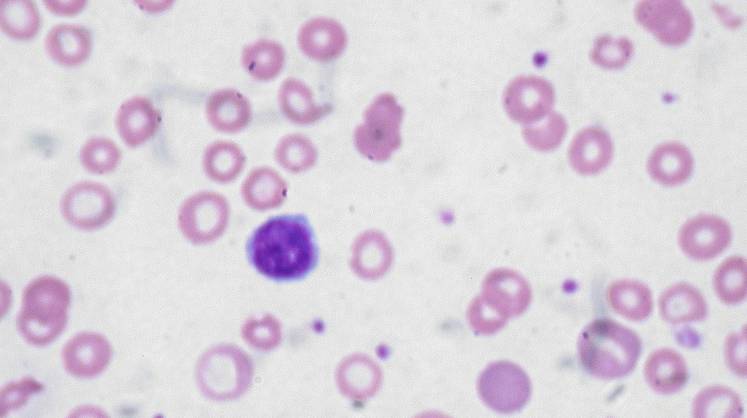
Ученые обнаружили связь между гемоглобином и слабоумием

Новое исследование показало, что последствия анемии выходят далеко за рамки привычных усталости, одышки и бледности кожи. Это состояние, вызванное недостатком гемоглобина, может поражать мозг, повышая риск развития деменции на 66% и связываясь с более высокими уровнями биомаркеров болезни Альцгеймера. Об этом пишет Medicalxpress, со ссылкой на публикацию в журнале JAMA Network Open.
Ученые из Швеции и Италии провели долгосрочное наблюдение за 2282 взрослыми старше 60 лет (без деменции на старте) из Стокгольма. Они измерили уровень гемоглобина и биомаркеры нейродегенерации, после чего следили за участниками каждые 3–6 лет на протяжении более чем десяти лет.
За период наблюдения (в среднем 9,3 года) деменция развилась у 362 человек. У тех, кто страдал анемией в начале исследования, вероятность деменции оказалась выше на 66%. Кроме того, низкий уровень гемоглобина связали с повышенными уровнями трех ключевых биомаркеров: p-tau217 (накапливается при болезни Альцгеймера), NfL (маркер повреждения нервных клеток) и GFAP (сигнал воспаления в мозге). У людей с анемией и высоким уровнем NfL риск деменции возрастал в 3,5 раза. Связь была сильнее у мужчин, чем у женщин.
Одно из основных объяснений, почему анемия вредит мозгу, — хроническое снижение поступления кислорода в мозг, что вызывает длительную нагрузку на клетки, повреждает сосуды и ведет к потере нейронов. Исследования с помощью визуализации показывают уменьшение объема мозга и признаки повреждения тканей у людей с анемией.
Анемия поражает примерно каждого десятого человека старше 65 лет. Исследователи полагают, что это состояние может быть клинически важным фактором риска развития деменции — потенциально изменяемым. Необходимы дальнейшие исследования, чтобы выяснить: может ли скрининг на анемию и ее своевременное лечение помочь предотвратить снижение когнитивных функций.
Как писал ранее «Монокль», порядка 50 млн человек в мире живут с деменцией, и, по прогнозам, к 2050 году это число утроится. Однако воздействие на ключевые факторы риска, часть из которых связана с образом жизни, потенциально может предотвратить развитие заболевания в 40% случаев. Специалисты Британского биобанка (UK Biobank) выявили 11 ключевых факторов, связанных с повышенным риском развития деменции: возраст; низкий уровень образования; история диабета; история либо текущая депрессия; история инсульта; родительское слабоумие; экономический недостаток (индекс депривации Таунсенда); высокое кровяное давление; высокий уровень холестерина; живет один; мужской пол.